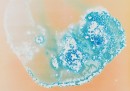

Le droghe viste da vicinissimo
Cosa succede se mettiamo droghe e medicine su una pellicola fotografica, mostrato in un progetto di un'artista tedesca
di Antonella Vendola – @antonellaven
L’artista tedesca Sarah Schoenfeld è cresciuta con un padre affetto da disturbi mentali e che per tutta la vita ha fatto uso di psicofarmaci. Questa circostanza, ha spiegato Schoenfeld in un’intervista, l’ha spinta a farsi domande su quale sia la nostra “vera” identità: se assumiamo psicofarmaci che, per esempio, alterano il nostro umore, siamo ancora noi stessi? E le droghe? Quanto queste cose influenzano la nostra identità e la nostra personalità? Sarah Schoenfeld si è chiesta queste cose anche quando, negli anni Novanta, iniziò a frequentare club e locali di Berlino e scoprire – direttamente o indirettamente – come la droga altera i sensi e la percezione del mondo. Ha deciso allora di dare una rappresentazione grafica delle molecole che compongono le droghe, alla base di quei processi chimici che possono rimettere in discussione le nostre certezze su quella che normalmente chiamiamo “identità”: ciò che rende noi stessi proprio noi stessi e non un’altra persona.
Per realizzare il lavoro “All you can feel“, Sarah Schoenfeld ha lasciato cadere gocce di diverse droghe e farmaci – come eroina, speed, caffeina, valium – direttamente su pellicole fotografiche che erano già state esposte alla luce, lasciando che i composti chimici interagissero con quelli delle pellicole. I negativi così impressionati sono stati poi ingranditi fino a ottenere stampe di 160×200 attraverso un nomale processo di ingrandimento fotografico. Il risultato è una serie di “fotografie” diversissime tra di loro poichè ogni reazione chimica ha prodotto colori, forme e sfumature diverse: come le droghe alterano la percezione del mondo, così in “All you can feel” alterano i processi chimici fotografici, normalmente innescati dalla luce sulla pellicola, che ci fanno considerare tutte le fotografie “sullo stesso livello” e quindi, in un certo senso, rappresentazioni oggettive della realtà.